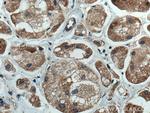
AURKA Antibody in Immunohistochemistry (Paraffin) (IHC (P))

Search
Proteintech
AURKA Monoclonal Antibody (1F4B10)
{{$productOrderCtrl.translations['antibody.pdp.commerceCard.promotion.promotions']}}
{{$productOrderCtrl.translations['antibody.pdp.commerceCard.promotion.viewpromo']}}
{{$productOrderCtrl.translations['antibody.pdp.commerceCard.promotion.promocode']}}: {{promo.promoCode}} {{promo.promoTitle}} {{promo.promoDescription}}. {{$productOrderCtrl.translations['antibody.pdp.commerceCard.promotion.learnmore']}}
产品信息
66757-1-IG
宿主/亚型
分类
类型
克隆号
抗原
偶联物
形式
浓度
规格
保存条件
运输条件
产品详细信息
Aliquoting is unnecessary for -20°C storage.
靶标信息
AURKA (Aurora A) is a serine/threonine kinase that regulates mitosis by association in vivo with centrosomes. Overexpression of AURKA is observed in many types of cancer. Aurora A plays a role in cell cycle regulation during anaphase and/or telophase, in relation to the function of the centrosome/spindle pole region during chromosome segregation. Aurora A plays a key role during tumor development and progression and is overexpressed in many human cancers including breast, ovarian and colorectal. Aurora A is viewed as a potential target for anticancer drug treatment. Tissue specificity: Highly expressed in testis and weakly in skeletal muscle, thymus and spleen.
仅用于科研。不用于诊断过程。未经明确授权不得转售。